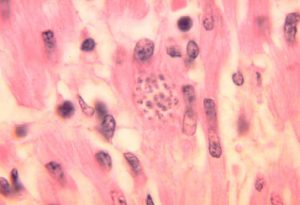

Trypanosomen allgemein
Trypanosomen und Nagana
Trypanosoma brucei und die Schlafkrankheit
Trypanosoma cruzi wurde erstmals 1909 vom brasilianischen Arzt Carlos Chagas beschrieben und nach dem Arzt Oswaldo Cruz benannt. Der Einzeller hat eine einzelne Geißel sowie einen großen Kinetoplasten. Der Parasit kommt in mehreren Formen vor, die sich morphologisch unterscheiden:
Die trypomastigote (länglich, gewundene) Form mit Geißelbasis nahe dem Zellkern ist im Mittel 20 Mikrometer lang, hat eine lange Geißel und ein spitzes Hinterende.
Die amastigote Form ist bis 4 Mikrometer lang, die Geißel ist fast unsichtbar.
Die epimastigote Form ist der trypomastigoten ähnlich, die Geißelbasis ist aber in einer anderen Position.
Der für die Arten der Kinetoplastea charakteristische Kinetoplast ist eine Ansammlung von DNA innerhalb eines großen Mitochondriums.
Es werden aufgrund biochemischer Unterschiede zwei Subtypen von T. cruzi unterschieden, der relativ homogene Typ I sowie der Typ II, der nach molekulargenetischen Analysen weiter in IIa-e unterteilt wurde. Die Typen, die derzeit keinen taxonomischen Rang haben, unterscheiden sich nicht nur molekular, sondern unter anderem auch in der typischen Wirtsart. Die Bezeichnung Trypanosoma cruzi cruzi als Unterart für alle humanpathogenen Isolate ist nicht mehr gebräuchlich. Die Unterart Trypanosoma cruzi marinkellei wurde aus südamerikanischen Fledermäusen isoliert.
Trypanosoma cruzi ist in Süd- und Mittelamerika von Mexiko bis zum südlichen Argentinien verbreitet, insbesondere arme, ländliche Gebiete sind betroffen. Infizierte Tiere werden aber auch in den USA gefunden.
Bei den Insekten sind Raubwanzen der Unterfamilie Triatominae Zwischenwirte, insbesondere Arten der Gattungen Rhodnius und Triatoma. Der wichtigste Vektor bei der Infektion von Menschen ist Triatoma infestans. Unter den Säugetieren sind unter anderem Haustiere wie Hund und Katze, aber auch hausnah lebende Nagetiere wichtige Wirte, während unter den Wildtieren Opossums (für T. cruzi Typ I) und Gürteltiere (für T. cruzi Typ II) die wichtigsten Reservoirs sind.
Im Darm der Raubwanzen wandelt sich der bei einer Blutmahlzeit aufgenommene Parasit von einem Trypomastigot zu einem Epimastigot um; diese können sich im Verdauungstrakt der Wanze durch Teilung vermehren. Im Enddarm der Wanzen entstehen aus den Epimastigoten wiederum neue Trypomastigote, die mit dem Kot ausgeschieden werden und Säugetierwirte durch Hautverletzungen oder Schleimhäute infizieren können.
In Säugetieren kommen die Parasiten als Trypomastigote im Blutstrom oder als Amastigote im inneren von Körperzellen vor. Nach der Infektion sind meist Makrophagen in der Haut das erste Ziel. Die intrazellulären Amastigoten können sich im Zytoplasma der Wirtszelle durch Teilung vermehren und nach erneuter Umwandlung in Trypomastigote die Wirtszelle zerstören. Damit gelangen sie wieder in die Blutbahn und können weitere Körperzellen des Wirbeltierwirtes, unter anderem Herzmuskelzellen, oder eine neue blutsaugende Raubwanze infizieren.
Von Mensch zu Mensch ist auch eine Übertragung von Trypomastigoten durch Bluttransfusionen und Organtransplantationen sowie durch die Plazenta von der Mutter auf den Fötus möglich.
Die Chagas-Krankheit ist hauptsächlich in Mittel- und Südamerika verbreitet und wird durch den Kot blutsaugender Raubwanzen übertragen.Die Raubwanzen infizieren sich auch gegenseitig durch Koprophagie und „Kannibalismus“. Ein Erregerreservoir besteht u. a. bei freilebenden Tieren (z. B. Gürteltieren, Opossums, Zweifinger-Faultieren), aber auch bei Hunden, Katzen und Ratten. Auch der infizierte Mensch ist ein wichtiges Parasitenreservoir. Insgesamt soll es mehr als 18 Millionen Infizierte geben. In Bolivien könnte etwa ein Viertel der Bevölkerung betroffen sein. Jährlich gibt es 50.000 Neuinfektionen und 15.000 Todesfälle.
Durch Migration, Tourismus und Bioinvasion der Raubwanzen durch Warentransport kann die Krankheit auf anderen Kontinenten eingeschleppt und in seltenen Fällen dort durch Blutspenden verbreitet werden. In Spanien, wo über 200.000 Einwanderer aus Lateinamerika leben, gibt es geschätzt zirka 6000 Infizierte. In den USA könnten mehrere 100.000 Einwanderer infiziert sein. Dort gibt es drei gesicherte Fälle von Chagas-Erkrankungen durch Blutkonserven, 2006 war bei Routinetests eine von 4655 überprüften Blutkonserven positiv.
Im Mai 2012 meldete Uruguay die Ausrottung der übertragenden, in Südamerika als Vinchuca bezeichneten Raubwanze.
Die Krankheit wird von der Weltgesundheitsorganisation (WHO) als vernachlässigte Krankheit bezeichnet, also als eine hauptsächlich arme Menschen betreffende Krankheit, zu deren Erforschung und Bekämpfung nur wenig Geld bereitgestellt wird, obwohl sie weit verbreitet ist und gravierende Folgen für die Erkrankten und die gesamte Gesellschaft hat.
Die Chagas-Krankheit tritt beim Menschen in vier Stadien auf: Nach dem Stich der Raubwanze tritt meist eine Schwellung um die vom Insekt erzeugte Stichwunde auf: Ein Ödem mit Entzündungserscheinungen, oft in Augennähe (Romana-Zeichen oder romanasches Zeichen). Es können aber auch andere Körperstellen betroffen sein, die sich später evtl. gar nicht mehr identifizieren lassen.
Eine akute Phase tritt bei ca. einem Drittel der Neuinfizierten auf. Es handelt sich meist um Kinder oder Personen mit Abwehrschwäche. Diese Phase klingt gewöhnlich nach ca. vier Wochen wieder ab. Fieber, Atemnot, Ödeme, Durchfall, Bauchschmerzen, Lymphknotenschwellungen, Krampfanfälle bei Einschluss des Gehirns und Herzvergrößerung sind die Folge.
Nach einer Latenzphase, die u. U. Jahre dauern kann, kommt es zur chronischen Erkrankung. Symptome der akuten Phase können aber auch während der Latenzphase wieder ausbrechen, wenn eine neu auftretende Abwehrschwäche hinzukommt, z. B. durch eine HIV-Infektion.
Die Symptome der chronischen Phase entstehen vorwiegend aus der chronischen Herzvergrößerung (Herzrasen, Leistungsschwäche, Luftnot bei Belastung) und der Zerstörung von Nervenzellen im Verdauungstrakt. Dies führt zu einer massiven Auftreibung insbesondere von Speiseröhre (Megaösophagus) und Dickdarm (Megacolon). Hierdurch ist eine normale Darmpassage nicht mehr möglich. Dies kann zum Tod durch Darmdurchbruch, Darmverschluss (Ileus) oder Bauchfellentzündung (Peritonitis) führen.
Unbehandelt kann die Chagaskrankheit in bis zu 10 % der Fälle tödlich enden. Besonders gefährdet sind Säuglinge und Kleinkinder.
Die Erkrankung ist benannt nach dem brasilianischen Arzt und Infektiologen Carlos Chagas, der den Erreger 1907 entdeckte und die Krankheit 1909 erstmals beschrieb. Bis in die 1960er Jahre wurde die Krankheit allerdings noch nicht als großes epidemiologisches Problem gewertet. Chagas erkannte Flagellaten im Darm von Triatominae und bewies, dass jene durch den Stich der Wanze auf Affen übertragen werden können. Chagas benannte den Parasiten nach Oswaldo Cruz, einem bekannten brasilianischen Arzt und Epidemiologen, nach dem auch das Institut, an dem er arbeitete, benannt ist.
Als herausragend bei der Arbeit von Chagas gilt, dass er allein den kompletten Mechanismus der Krankheit beschrieben hat: das auslösende Pathogen, den Vektor, den Wirt, die klinische Manifestation und die Epidemiologie.
Lange hielt Chagas den Stich fälschlich für die Hauptinfektionsquelle:
„Durch unwiderlegbare Versuche […] ist es bewiesen, dass der Triatomstich den natürlichen Mechanismus der Übertragung des Trypanosoms darstellt. Brumpt behauptet zwar, dass die Übertragung sich vorzugsweise durch Stuhlablagerung in Haut und Schleimhaut des Menschen vollzieht, doch glaube ich, dass dieser sicherlich mögliche Prozess eine Ausnahme bildet: der Insektenstich ist der biologische Infektionsprozess dieses Trypanosoms.“
1969 beschrieb der britische Parasitologe Ralph Lainson die Krankheit als erster vollständig korrekt. Er entdeckte, dass durch blutsaugende Triatominae verunreinigte Lebensmittel die Krankheit übertragen.